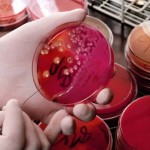

Dos pacientes con VIH que fueron sometidos a trasplantes de médula ósea para el cáncer han dejado la terapia anti-retroviral y todavía no muestran signos detectables del virus VIH, dijeron el miércoles investigadores.
Los investigadores de la Universidad de Harvard subrayaron que era demasiado pronto para decir que los hombres se han curado, pero dijo que era una señal alentadora.
Los investigadores, Timothy Henrich y Daniel Kuritzkes del Brigham afiliado a Harvard y el Hospital de Mujeres en Boston, anunció el año pasado que las muestras de sangre tomadas de los hombres – que ambos tenían cancer de sangre no mostraran rastros del virus HIV en ocho meses después de haber recibido transplantes de médula para reemplazar las células sanguíneas cancerosas con las células de donantes sanos.
«Lo están haciendo muy bien», dijo Henrich. «Aunque estos resultados son interesantes, pero no indican que los pacientes están curados. Sólo el tiempo lo dirá.»
El virus VIH puede estar escondido en otros órganos como el hígado, el bazo o el cerebro y podría regresar meses más tarde, advirtió.
Más pruebas de células, plasma y tejidos de los pacientes, por lo menos durante este año ayudará a dar una idea más clara sobre el impacto del trasplante en la persistencia del VIH, dijo.
La primera persona que informó de curarse del VIH, el estadounidense Timothy Ray Brown, se sometió a un trasplante de células madre en el año 2007 para el tratamiento de la leucemia. Fue informado por sus médicos alemanes que se habia curado de VIH dos años más tarde.
Médicos de Brown usaron un donante que tenía una mutación genética rara que proporciona resistencia contra el VIH. Hasta ahora, nadie ha observado resultados similares utilizando células de donantes normales, como las dadas a los dos pacientes de Boston.
Kuritzkes dijo que los pacientes se ponen de nuevo en las drogas si hay un rebote viral.
Un rebote mostrará que otros sitios son importantes reservorios de virus infecciosos y nuevos enfoques para medir serán necesarios estos reservorios en el desarrollo de una cura, dijo Henrich.
«Estos resultados proporcionan una claridad nueva información importante que bien podría cambiar el pensamiento actual sobre el VIH y la terapia génica», Kevin Robert Frost, director ejecutivo de la Fundación de Investigación del SIDA, dijo en un comunicado. «Mientras que el trasplante de células madre no es una opción viable para las personas con VIH en una amplia escala, debido a sus costos y la complejidad, estos nuevos casos podrían nos llevan a nuevos enfoques para el tratamiento, y en última instancia incluso erradicar, el VIH.»






